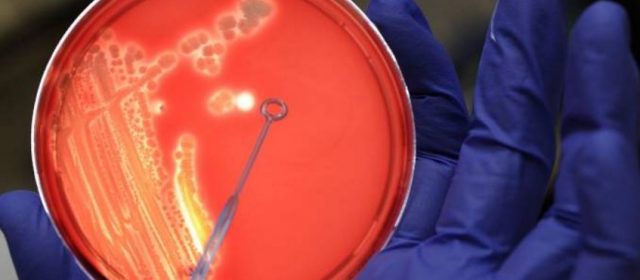

Il caso di E.Coli scoppiato nei mesi scorsi negli Stati Uniti, dovuto ad alcune verdure contaminate presenti nelle insalate di pollo dell’insegna Costco, piuttosto che al pollo stesso, come sospettato inizialmente, è stato ampliato alla farina. La General Mills Inc. (GIS – Nyse), il piu’ grande poduttore di cereali negli Stati Uniti, martedì 31 maggio, tramite le principali testate americane ha comunicato di avere effettuato un richiamo volontario: si stima intorno ai 10 milioni di libbre di farina, dopo le preoccupazioni espresse dai clienti che hanno utilizzato i prodotti della società e che hanno riferito di essersi ammalati nel corso degli ultimi cinque mesi a causa del batterio E. coli. General Mills ha inoltre riferito che le autorità locali e federali sono a conoscenza in tutto di 38 diversi casi scoperti tra il 21 dicembre 2015 e il 3 maggio 2016 in 20 stati differenti, relativi a uno specifico tipo di E. coli (E. coli O121).
La Fda sostiene che il numero di persone intossicate potrebbe aumentare nelle prossime settimane, dato che le malattie trasmesse per via alimentare tendono ad impiegare più tempo per manifestarsi. Durante le indagini per rintracciare la causa della malattia, il Centers for Disease Control and Prevention ha concluso che circa la metà degli individui intervistati ha denunciato di avere “preparato qualcosa in casa con la farina prima di ammalarsi” di cui almeno la metà aveva fatto uso della farina della General Mills. Sebbene la maggior parte dei ceppi di E. coli sono innocui, E. coli O121 è un batterio potenzialmente mortale. Il richiamo comprende sei tipi di farina con marchio Gold Medal, Wondra and Signature Kitchen. I prodotti portano i seguenti numeri UPC: 000-16000-18980, 000-16000-10710, 000-16000-10610, 000-16000-10410, 000-16000-19610, 000-21130-53001, 000-21130-53022 e 000-16000-11710. I medici chiamati in causa hanno riferito che la specie di batterio in questione, ovvero E.coli O121, potrebbe portare seri rischi alla vita delle persone, anche se fortunatamente fino ad ora non c’è stato nessun caso di decesso. A differenza dell’ Escherichia coli O157: H7 , un altro sierotipo patogeno di E. coli, poco si sa degli effetti sulla salute pubblica dello O121. Il caso arriva sulla scia di un’ altra recente epidemia di E. coli scoppiata nei ristoranti Chipotle. Il batterio killer, evidenzia Giovanni D’Agata, presidente dello “Sportello dei Diritti“, può essere venuto dall’acqua usata per la coltivazione oppure dal seme.
È la pianta di origine che può contaminarsi quando è ancora in campo, e il batterio passa, in fase dormiente, al seme. Poi, una volta messo a coltura, il batterio rinasce. Quindi bisogna risalire ai semi, andare a cercare queste aziende agricole e capire da quali coltivazioni arriva il batterio, perché il germoglio non può certo far crescere il batterio autonomamente, qualcosa lo deve aver contagiato. Alla luce delle notizie provenienti dagli Stati Uniti sull’epidemia di E. coli, l’Europa potrebbe vietare le importazioni di farina di questo lotto proveniente dagli Stati Uniti.